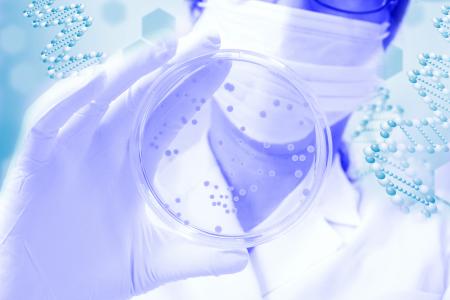
La nouvelle approche est basée sur le ciblage de la paroi bactérienne et sur le « confinement » physique de la bactérie

ANTIBIOTIQUES : L’autre façon d'avoir la peau de la bactérie
Une nouvelle façon, presque "mécanique" de tuer les bactéries, c’est ce que nous propose cette équipe de l’Université McMaster et de Montréal. Ce concept clinique prometteur dans la lutte contre la résistance aux antimicrobiens, basé sur le ciblage de la paroi bactérienne et sur le « confinement » physique de la bactérie, et présenté dans la revue Nature, annonce le développement d’une nouvelle classe d'antibiotiques dotés d’un tout nouveau mode d’action.
Le principe décrit dans ces travaux est celui de la « nouvelle molécule » corbomycine et de la complestatine moins connue : « La complestatine et la corbomycine sont des antibiotiques qui s’attaquent au peptidoglycane, la composante principale de la paroi cellulaire essentielle au développement et à la survie de presque toutes les bactéries », explique le co-auteur, Yves Brun, du Département de microbiologie, infectiologie et immunologie de l’Université de Montréal. « Ces deux antibiotiques inhibent l’action des autolysines nécessaires à la croissance et la division cellulaires ». Elisabeth Culp, co-auteur de l’étude, candidate au doctorat en biochimie et sciences biomédicales à l'Université McMaster nous explique ce principe autrement : « l’antibiotique tue les bactéries en bloquant la fonction de la paroi cellulaire bactérienne. Comme les bactéries ne parviennent plus à se diviser, elles deviennent de plus en plus fragiles, elles se transforment en longs filaments ce qui agit sur leur capacité à se reproduire ».
Une nouvelle famille d'antibiotiques qui s’inspire des glycopeptides
Pour identifier cette nouvelle stratégie antibactérienne, les chercheurs canadiens ont analysé l'arbre généalogique des glycopeptides déjà connus, étudié les gènes de ceux qui ne présentent pas de mécanismes de résistance connus, avec l'idée qu'ils pourraient alors apporter une autre manière de tuer les bactéries. En effet « si les gènes qui fabriquaient ces antibiotiques étaient différents, leurs armes anti-bactéries étaient peut-être également différentes ». Cette analyse confirme que cette nouvelle classe d’antibiotiques œuvre différemment, en ciblant la paroi bactérienne-comme expliqué plus haut.
La preuve chez la souris : les chercheurs démontrent ici que ces nouveaux antibiotiques peuvent bloquer les infections causées par le Staphylococcus aureus résistant aux médicaments.
« Pour qu'une cellule grandisse, elle doit se diviser et s'étendre. Si vous la bloquez complètement, elle est comme piégée dans une prison elle ne peut pas se développer ou se multiplier » : ces travaux révèlent ainsi un nouveau mode d’action possible pour les antibiotiques et cela pour la première fois depuis des décennies. L’approche peut, de plus être appliquée à d'autres antibiotiques, permettre d’en découvrir de nouveaux avec différents mécanismes d'action. Enfin, il y a un bonus ! Les bactéries exposées à ces antibiotiques ne développeront pas de résistance significative.
Autres actualités sur le même thème
ULCÈRE DIABÉTIQUE : Des pansements chargés d’oxyde nitrique à libération ajustée
Actualité publiée il y a 7 années 3 semainesINFECTIONS NOSOCOMIALES : Et si l’on s’attaquait à leur persistance ?
Actualité publiée il y a 7 années 9 moisPLAIES CHRONIQUES : Le derme artificiel qui bascule le génome de la plaie vers la cicatrisation
Actualité publiée il y a 9 années 2 moisSOIN des PLAIES : Des nanoparticules d'argent au chocolat
Actualité publiée il y a 9 années 1 moisLe « chocolat », une véritable option dans la lutte contre l'infection ? Parmi les produits naturels documentés comme efficaces dans le traitement de plaies,...



